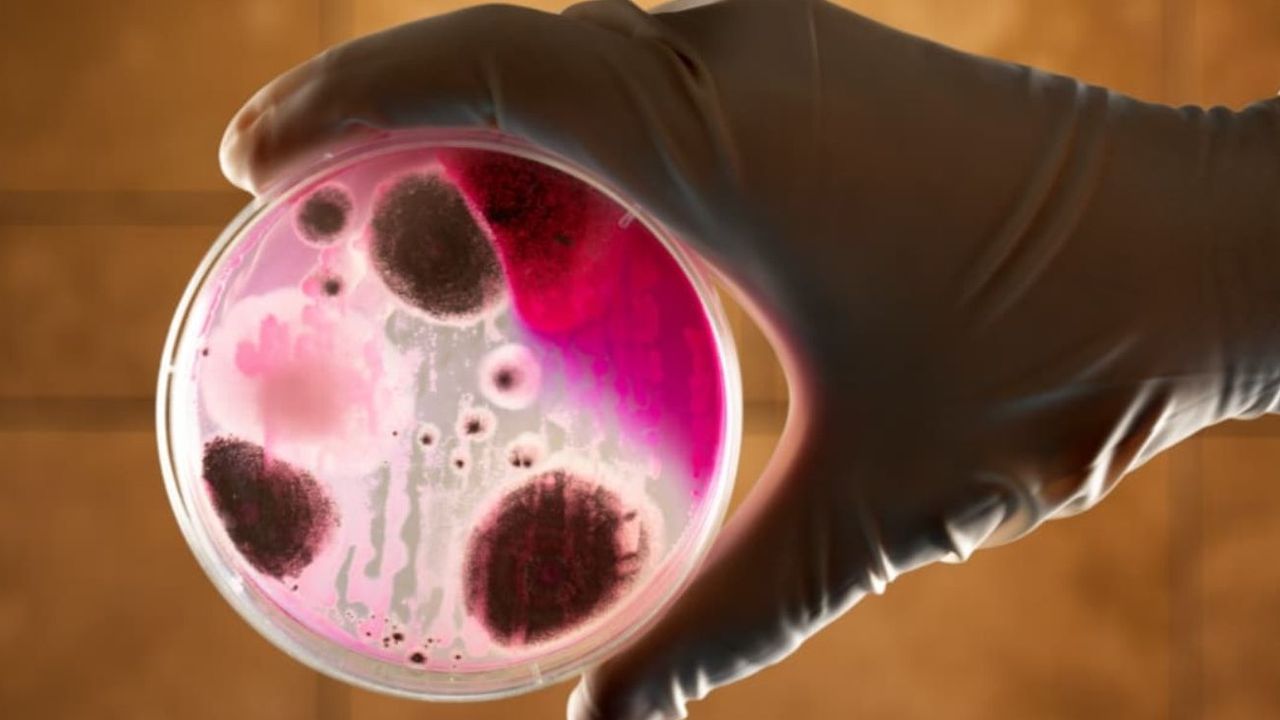

Bu blog yazısında, şarbonun tıp dünyasındaki yeri, nasıl bulaştığı, mikrobiyolojik özellikleri, tedavi yöntemleri ve çok daha fazlasını anlaşılır bir dilde bulabilirsiniz.
Tıp Dünyasında Şarbonun Yeri
Şarbon, özellikle bakteriyel enfeksiyonlar arasında önemli bir yere sahiptir. Canlılarda ciddi hastalıklara yol açabilir ve özellikle sığır, koyun, keçi gibi çiftlik hayvanları arasında yaygındır. İnsanlarda ise nadir görülür, fakat bulaştığında ciddi sağlık sorunlarına yol açabilir.
- Cilt şarbonu (en yaygın türü)
- Akciğer (inhalasyon) şarbonu
- Bağırsak (gastrointestinal) şarbonu
Her bir formun belirtileri ve şiddeti değişkenlik gösterebilir. Özellikle solunum yoluyla bulaşan şarbon tipleri daha tehlikeli kabul edilir.
Nasıl Bulaşır?
Şarbonun bulaşma yolları, hastalığın hangi formuna maruz kalındığına göre değişebilir:
- Deriden: Enfekte hayvanların derisine, yününe veya etine temas yoluyla
- Solunum yoluyla: Şarbon sporlarının havada asılı kalması ve solunması
- Ağız yoluyla: Enfekte hayvan ürünlerinin (et/yün) tüketilmesi
İnsandan insana bulaşması son derece nadirdir. Daha çok mesleki maruziyet riskiyle karşı karşıya kalan veterinerler, kasaplar ve çiftçilerde rastlanır.
Kısaca Şarbon
Şarbon, Bacillus anthracis adındaki bir bakteri tarafından oluşturulan, hızlı seyreden ve tedavi edilmediğinde ölümcül olabilen ciddi bir hastalıktır. Kısacası; doğadan, enfekte hayvanlardan veya onların ürünlerinden insanlara geçerek cilt, akciğer veya bağırsakları etkileyen bir bakteriyel enfeksiyon türüdür.
Bulmacada Şarbon: Anlamı ve Eş Anlamları
Türkçe bulmacalarda "şarbon" kelimesi bazen kara yara olarak karşımıza çıkabilir. Ayrıca, tıp terminolojisinde ise "antraks" kelimesiyle eş anlamlıdır. Kısacası:
- Kara yara
- Antraks
Bu kelimeler, özellikle bulmaca çözerken karşılaşabileceğiniz önemli eş anlamlılardır.
Tedavisi Nasıl Olur?
Şarbonun tedavisinde erken tanı ve antibiyotik tedavisi kritik rol oynar. Genellikle aşağıdaki tedavi yaklaşımları izlenir:
- Antibiyotikler: Penisilin, doksisiklin veya siprofloksasin gibi antibiyotikler tercih edilir.
- Destekleyici tedavi: Gerekirse sıvı takviyesi, ağrı kesiciler ve yara bakımı uygulanabilir.
- Aşılama: Yüksek riskli meslek grupları için koruyucu şarbon aşısı önerilebilir.
Tedaviye geç başlanırsa özellikle akciğer şarbonunda ölüm oranı artabilir. Bu nedenle şüpheli temaslarda vakit kaybetmeden sağlık kuruluşuna başvurulmalıdır.
Mikrobiyoloji: Şarbonun Bilimsel Yüzü
Mikrobiyoloji açısından, şarbonun etkeni olan Bacillus anthracis, sporlu bir bakteridir. Sporlu yapısı, çevre koşullarına karşı yüksek dayanıklılık sağlar; toprakta yıllarca canlı kalabilir. Bu nedenle, enfekte olmuş hayvanların gömüldükleri topraklar dahi bulaşıcı potansiyel taşır.
Mikroskop altında büyük, çubuk şeklinde ve hareketsiz olarak gözlemlenir. Laboratuvarlarda yapılan testlerle kolaylıkla teşhis edilebilir.
Şarbon Etkeni Nedir?
Şarbon hastalığına neden olan temel mikrobiyolojik ajan Bacillus anthracis adını alır. Tabloyu inceleyerek Bacillus anthracis’in bazı temel özelliklerini görebilirsiniz:
| Özellik | Açıklama |
|---|---|
| Bakteri Türü | Gram-pozitif, aerobik, sporlu çubuk |
| Dayanıklılık | Sporları çevre koşullarında yıllarca canlı kalabilir |
| Bulaşma Yolu | Deriden, solunumdan veya ağız yoluyla |
| Enfeksiyon Kaynağı | Hasta hayvanlar ve onlarla temas eden materyaller |
Şarbon Anlamı Nedir?
"Şarbon" kelimesi, köken itibariyle Fransızca “charbon” (kömür) sözcüğüne dayanır. Bunun sebebi, cilt şarbonunda ortaya çıkan siyah yara lezyonlarıdır. Anlam olarak;
- Canlılarda görülen, Bacillus anthracis bakterisinin yol açtığı ciddi bir enfeksiyon hastalığı
- Halk arasında bazen kara yara şeklinde de adlandırılır
Şarbon Tozu: Medya ve Güvenlikteki Yeri
Şarbon tozu, genellikle biyolojik ajan olarak kullanılmasıyla gündeme gelir. Medyada sıkça karşılaşılan şarbon tozu, Bacillus anthracis sporlarının kuru forma getirilmiş halidir. Özellikle;
- Posta yoluyla gönderildiğinde (biyo-terör olayları)
- Havaya yayıldığında, solunum yoluyla maruziyette
Çok tehlikelidir ve inhale edildiğinde etkileri ciddi olabilir. Ancak gündelik yaşamda karşılaşılma riski oldukça düşüktür.
Şarbon hakkında toplu bilgiye sahip olmak, hem sağlığınızı korumanıza hem de yanlış bilgilere karşı önlem almanıza yardımcı olur. Güvenilir kaynaklardan bilgi almak ve şüpheli durumlarda sağlık profesyonellerine başvurmak önemlidir.